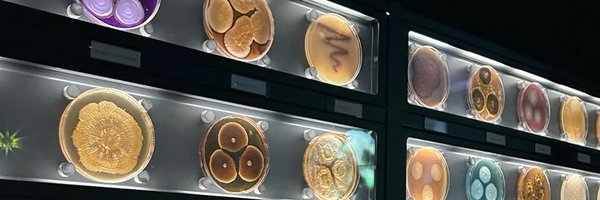
_RemasAbdullah Profile Banner

ree 🧫
@_RemasAbdullah
Followers
29
Following
76
Media
15
Statuses
20
CLS student 🔬🧪 KSUer #CLS446
Kingdom of Saudi Arabia
Joined July 2025
Part two: صبغتها وتقشرت مع المويا وانكسرت مالي حظ في��ا
0
0
7
in my 3rd year in uni and this is my first non arabic speaking/saudi dr 💔 i’m dreading Thursdays now
0
0
2
إِلَى اللَّهِ مَرْجِعُكُمْ ۖ وَهُوَ عَلَىٰ كُلِّ شَيْءٍ قَدِيرٌ
1
70
275
1/5 done! كنت من اللي صادف اختبارهم يوم التعليق واليوم اختبرته ولكن يهووون لانه بالفترة المسائية جمال
0
0
3
today was that one random day in the middle of practical finals when you’re forced to come to campus just to give a 5-minute presentation
0
0
1